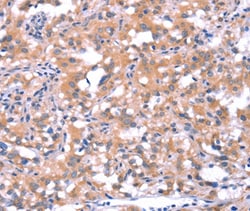
Invitrogen FAT1 Polyclonal Antibody 100 &mu;L | Buy Online | Invitrogen&trade; | Fisher Scientific

missing translation for 'onlineSavingsMsg'
Learn More
Learn More
Invitrogen™ FAT1 Polyclonal Antibody


Description
The antibody detects endogenous levels of total FAT1 protein.
This gene is an ortholog of the Drosophila fat gene, which encodes a tumor suppressor essential for controlling cell proliferation during Drosophila development. The gene product is a member of the cadherin superfamily, a group of integral membrane proteins characterized by the presence of cadherin-type repeats. In addition to containing 34 tandem cadherin-type repeats, the gene product has five epidermal growth factor (EGF)-like repeats and one laminin A-G domain. This gene is expressed at high levels in a number of fetal epithelia. Its product probably functions as an adhesion molecule and/or signaling receptor, and is likely to be important in developmental processes and cell communication. Transcript variants derived from alternative splicing and/or alternative promoter usage exist, but they have not been fully described.

Specifications
Specifications
| Antigen | FAT1 |
| Applications | Immunohistochemistry (Paraffin) |
| Classification | Polyclonal |
| Concentration | 2.4 mg/mL |
| Conjugate | Unconjugated |
| Formulation | PBS with 40% glycerol and 0.05% sodium azide; pH 7.4 |
| Gene | FAT1 |
| Gene Accession No. | Q14517 |
| Gene Alias | 2310038E12Rik; AU023433; Cadherin family member 7; cadherin FAT1 isoform +12; cadherin ME5; cadherin-related family member 8; cadherin-related tumor suppressor homolog; CDHF7; CDHR8; FAT; fat 1 cadherin; FAT atypical cadherin 1; FAT tumor suppressor 1; FAT tumor suppressor homolog 1; FAT tumor suppressor homolog 1 (Drosophila); FAT1; Fath; hFat1; ME5; mFat1; Protein fat homolog; protocadherin Fat 1; Protocadherin Fat 1, nuclear form |
| Gene Symbols | FAT1 |
| Show More |
Product Title
By clicking Submit, you acknowledge that you may be contacted by Fisher Scientific in regards to the feedback you have provided in this form. We will not share your information for any other purposes. All contact information provided shall also be maintained in accordance with our Privacy Policy.
Spot an opportunity for improvement?